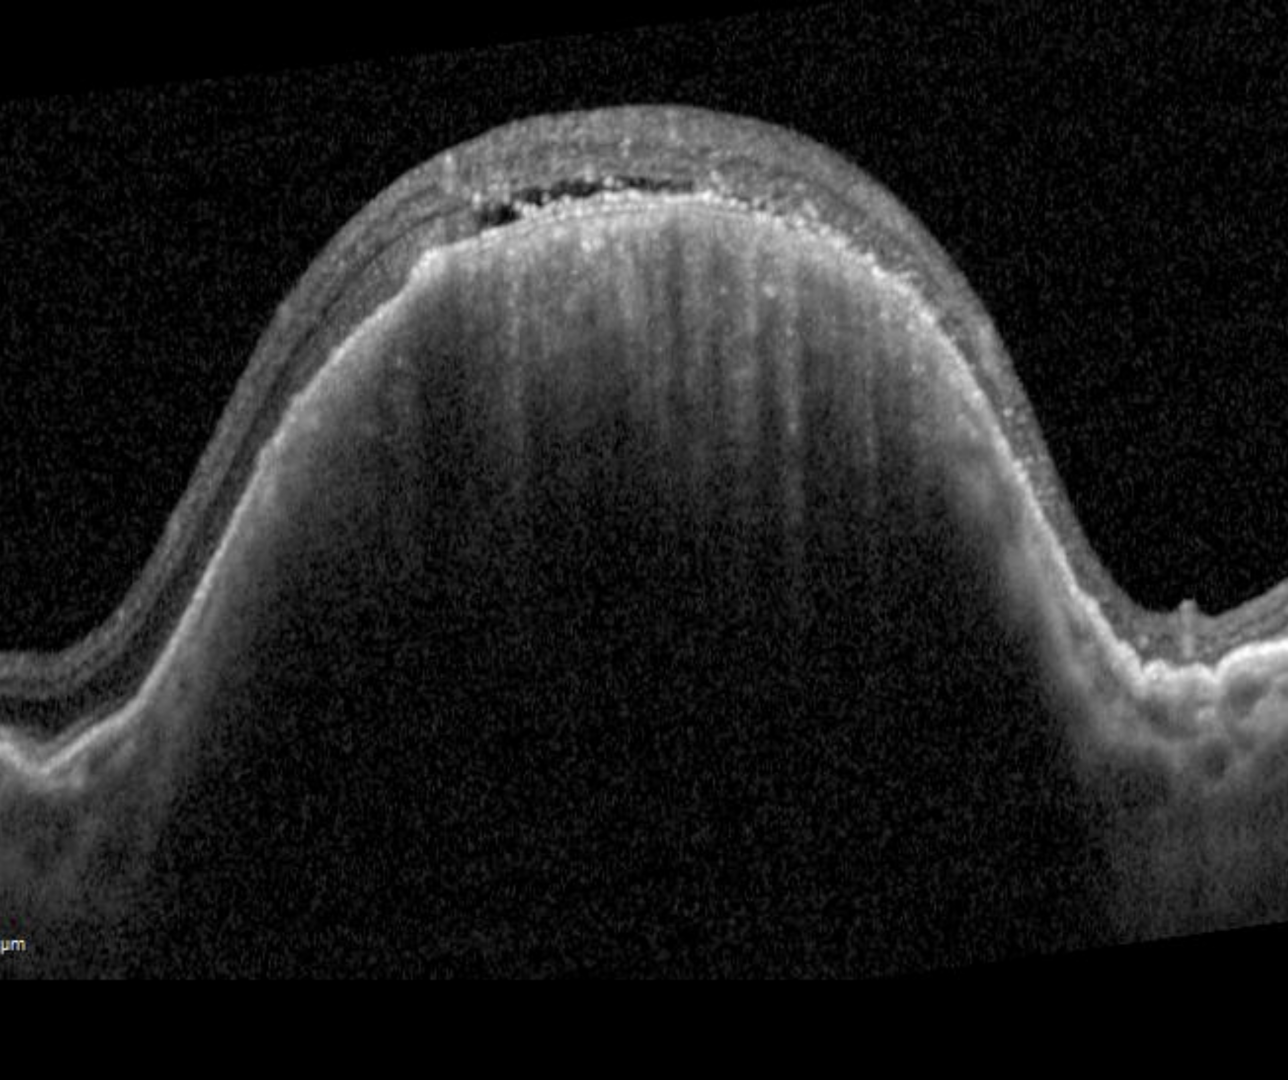

Overview
Within this chapter, we will explore the clinical signs and imaging characteristics of posterior eye lesions. To understand these conditions most effectively, it is helpful to first understand some basic terminology used when describing neoplasia.
The word "neoplasm" refers to the entire spectrum of tumours, whether they be benign, premalignant or malignant.
Terminology used when referring to changes in the cells include:
- Hypertrophy which refers to an increase in the volume of cells (ie: the cells are larger than normal)
- Hyperplasia which refers to the enlargement of an organ or tissue caused by the proliferation of cells (ie: more cells are present)
In terms of neoplasia, understanding the following terms will be helpful:
- A hamartoma is a benign tumour-like malformation that is composed of an abnormal mixture of tissue elements that develop and grow at the same rate as normal elements.
- An adenoma is a benign tumour of epithelial tissue with glandular origin, glandular characteristics or both.
- An adenocarcinoma is a malignant adenoma.
Finally, it is helpful to understand that there is often no clear delineation between "suspicious" benign lesions and malignant lesions, rather it is a spectrum of the one disease. We can identify certain features that are suspicious of malignancy but ultimately the presence of these suspicious features usually warrants a referral to an ophthalmologist or ocular oncologist.